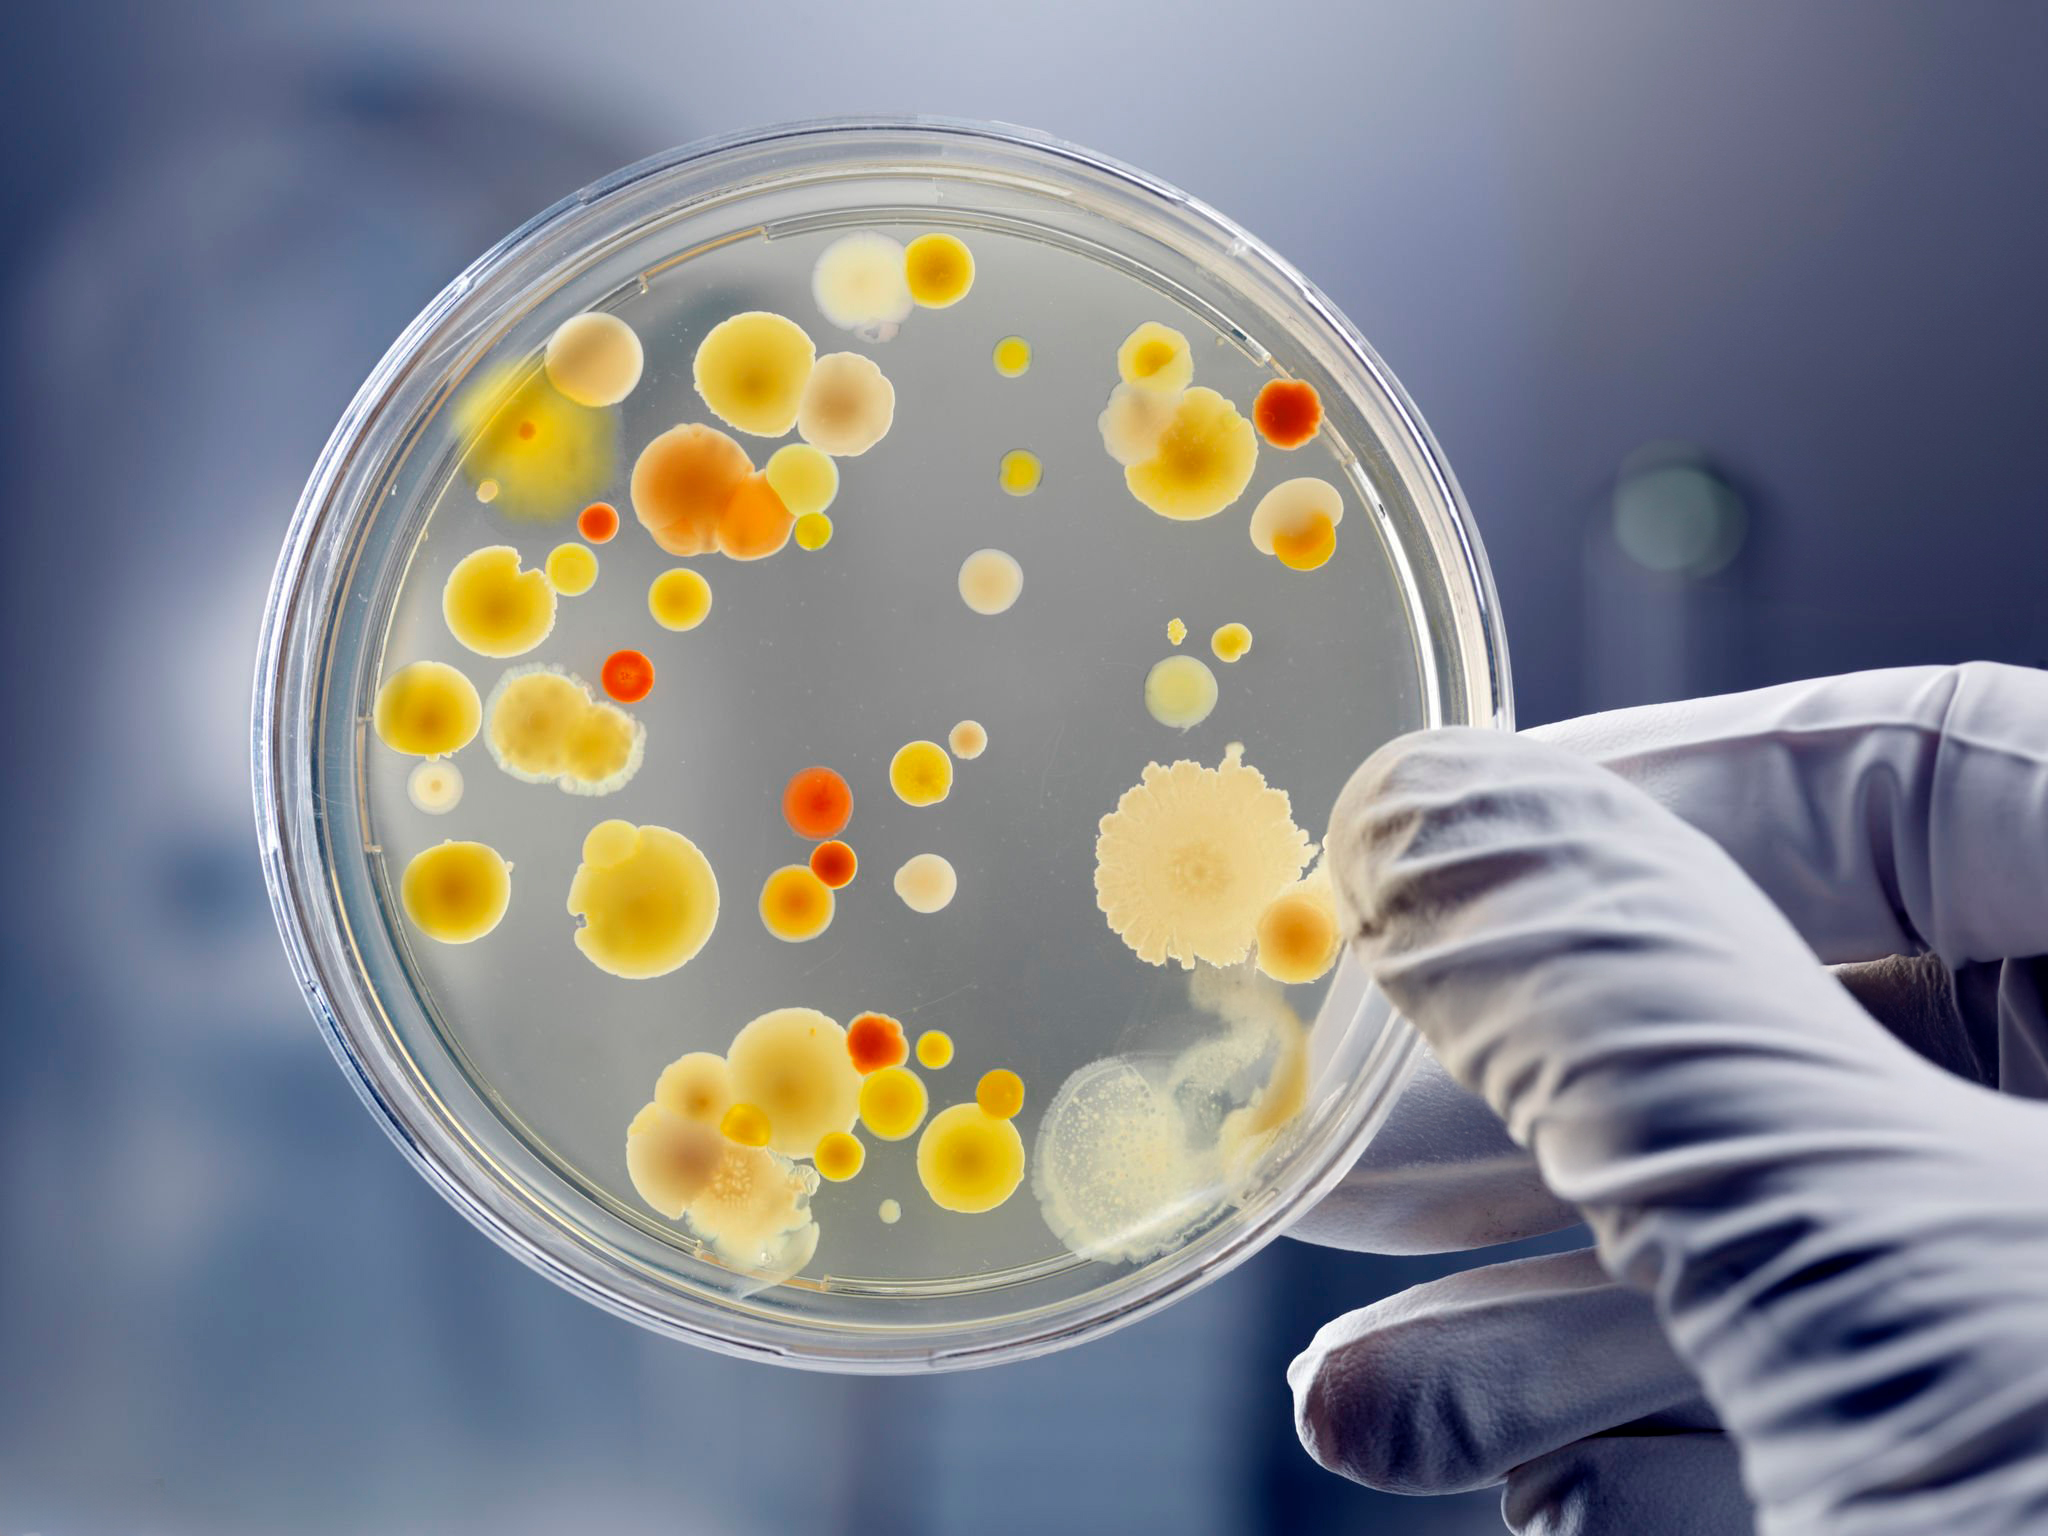
Laboratorio microbiológico

Nuestro Staff
Contamos con un equipo altamente capacitado y comprometido con la excelencia, quienes lideran con su experiencia y dedicación el trabajo de cada día. Sin embargo, nuestro éxito es el resultado del esfuerzo conjunto de todo nuestro personal, compuesto por un equipo de profesionales que trabajan para asegurar la calidad y seguridad de nuestros servicios.
Q.F. Elena Barrandeguy
Gerente de Calidad
Q.F. Ignacio Viera
Jefe de Control de Calidad
Q.F. Mariana Curuchet
Encargada de Control de Calidad Microbiológico
Q.F. Fiorella Gandolfo
Jefa de Aseguramiento de Calidad
Q.F. Romina Perdomo
Encargada de Validaciones y Desarrollo Analítico
Laboratorio de control de calidad Microbiológico
Nos especializamos en garantizar la seguridad y calidad microbiológica de sus productos. Ofrecemos una amplia gama de servicios diseñados para cumplir con los estándares más estrictos del sector.
- Control higiénico de materias primas, productos farmacéuticos y afines
- Análisis microbiológico de aguas
- Test de esterilidad
- Evaluación de eficacia de conservador
- Actividad bactericida en desinfectantes
- Monitoreos ambientales activos, pasivos y de superficie
- Asesoramiento Técnico
Laboratorio de control de calidad Fisicoquímico.
Comprometidos con el cumplimiento de la normativa GLP, ofrecemos resultados confiables que respaldan la calidad y eficacia de sus productos. Realizamos análisis fisicoquímicos de materias primas, productos farmacéuticos y afines, incluyendo diversas formas farmacéuticas como líquidos, suspensiones, comprimidos, cápsulas, cremas e inyectables.

- Análisis de materias primas activas y excipientes
- Determinación de agua por Karl Fisher
- Polarimetría
- Titulación potenciométrica
- Volumetrías acuosas y no acuosas
- Identificación por Infrarrojo (IR)
- Análisis de productos terminados: Dosificaciones, Disoluciones, Uniformidad de contenido en todas las formas farmacéuticas, Impurezas orgánicas , Sustancias relacionadas , Impurezas volátiles ( UV , HPLC , UHPLC , GC )
- Análisis de impurezas nitrosamínicas por HPLC-MASA
- Almacenamiento en cámaras de estabilidad
- Desintegraciones
- Polarimetrías
- Desarrollo y validación de técnicas analíticas

UHPLC con detector DAD

HPLC (Cromatografía liquida de alta presión, con detectores DAD, IR y conductividad)

GC (Cromatografía gaseosa con Head Space e inyección automática)

Cámaras de estabilidad natural y acelerada (en condiciones Zona II y Zona IV)

Espectrofotómetro IR

Espectrofotómetro UV

Titulación automática (potenciométrica y acuoso)

Equipos de Disolución

Karl Fisher para determinación de agua

